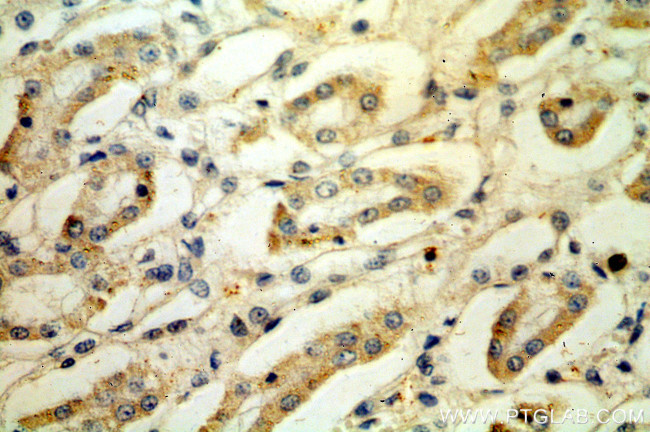
LY96/MD2 Antibody in Immunohistochemistry (Paraffin) (IHC (P))

Search
Proteintech
LY96/MD2 Polyclonal Antibody
{{$productOrderCtrl.translations['antibody.pdp.commerceCard.promotion.promotions']}}
{{$productOrderCtrl.translations['antibody.pdp.commerceCard.promotion.viewpromo']}}
{{$productOrderCtrl.translations['antibody.pdp.commerceCard.promotion.promocode']}}: {{promo.promoCode}} {{promo.promoTitle}} {{promo.promoDescription}}. {{$productOrderCtrl.translations['antibody.pdp.commerceCard.promotion.learnmore']}}
产品信息
11784-1-AP
种属反应
宿主/亚型
分类
类型
抗原
偶联物
形式
浓度
规格
纯化类型
保存液
内含物
保存条件
运输条件
产品详细信息
Immunogen sequence: MLPFLFFST LFSSIFTEAQ KQYWVCNSSD ASISYTYCDK MQYPISINVN PCIELKGSKG LLHIFYIPRR DLKQLYFNLY ITVNTMNLPK RKEVICRGSD DDYSFCRALK GETVNTTISF SFKGIKFSKG KYKCVVEAIS GSPEEMLFCL EFVILHQPNS N (1-160 aa encoded by BC020690)
靶标信息
MD-2 is a gene that encodes a protein involved in the recognition of bacterial lipopolysaccharides (LPS) by the immune system. It is located on chromosome 8 and is part of a larger family of genes that encode for similar proteins. The MD-2 protein forms a complex with Toll-like receptor 4 (TLR4) to recognize and respond to LPS, triggering an immune response. Mutations or variations in the MD-2 gene have been associated with various diseases and conditions, including sepsis and inflammatory disorders.
仅用于科研。不用于诊断过程。未经明确授权不得转售。
生物信息学
蛋白别名: cytokine; ESOP-1; Ly-96; Lymphocyte antigen 96; MD-2; myeloid differentiation protein-2; Protein MD-2
基因别名: ESOP-1; ESOP1; ly-96; LY96; MD-2; MD2
UniProt ID: (Human) Q9Y6Y9
Entrez Gene ID: (Human) 23643